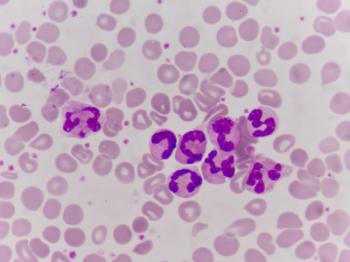

Cognitive behavioral therapy with exposure treatment might help but few people with AD receive any form of behavioral intervention, say Dorian Kern and colleagues from Karolinska Institutet, Stockholm.

Cognitive behavioral therapy with exposure treatment might help but few people with AD receive any form of behavioral intervention, say Dorian Kern and colleagues from Karolinska Institutet, Stockholm.

Researchers found an association between ADHD and three inflammatory conditions—atopic dermatitis, otitis media, and herpes simplex infection.


Training an AI model to identify LVSD from single-lead ECG data would allow more reliable, earlier diagnosis.

Scientists say it could lead to new drugs for vitiligo and other pigmentation diseases.

Results show that the new heart failure drug reduces the hospitalizations and risk of death from cardiovascular events.

The US accounted for nearly half of the atopic dermatitis drugs market in 2021. According to 2021 data from the National Center for Health Statistics, roughly 7% of adults in the U.S. have eczema.

Mayo Clinic researchers have developed a process that uses human cells as inks, dubbed bioinks, to print natural tissue-like structures in three dimensions.

Two studies show that high heart failure rates in the Black population are a legacy of discriminatory mortgage policies.


The study will enroll an estimated 1,000 patients, of whom approximately 200 will have vitiligo. The remaining participants will be at-risk family members, some 40 to 60 of whom are expected to develop vitiligo during the 5-year study.

The pause was recommended by an independent data safety monitoring board, according to a company press release.

A study in statin-intolerant patients suggests that bempedoic acid reduces the risk of major cardiovascular events significantly.

Results reported in JAMA Dermatology today show disagreement between physicians and patients in the grading of skin disease. Physicians tend to see severity relative to other patients, note the researchers, while patients may compare themselves with peers and their social circle.

The guidelines strongly recommend topical corticosteroids for adults, as well as the intermittent use of medium-potency topical corticosteroids as maintenance therapy (two times per week) to reduce disease flares and relapse.

Study suggests that low-fat meals may affect blood concentration levels, and high blood concentration has been correlated with a better response to the drug.

Findings from the ADAURA trial argue for starting treatment with the AstraZeneca drug early, says Yale’s Roy Herbst, M.D., Ph.D., the principal investigator.

In a clinical trial, researchers concluded that direct oral anticoagulants were non-inferior to low-molecular-weight heparin.

Some factors found in previous investigations, such as stroke, were not significant in this study, while treatment interruption and severe tricuspid valve regurgitation were newly identified.

Positive results from a small study suggest that whey protein could have some benefits for people with heart failure, although it is a preliminary finding. Whey protein has a high concentration of leucine, which may help build muscle.

Study shows that every 5% increment in the cardiovascular disease risk as measured by the 10-year Framingham risk score was related to lower cognitive function.

Exposure to second-hand smoke may be more harmful for young children than adults because of their faster respiratory rate.

Researchers using data from prospective cohort studies identify higher levels of diglycerides and triglycerides in the blood as possibly playing an important role in the multifactorial causation of glaucoma.

Findings reported in JAMA Opthalmology show substantial decrease from 30 years ago.
Researchers in Spain explore strategies for making tumor microenvironment less “tumor permissive.” Their experiments were in mice models of the lung cancer, so the findings are from early-stage research and far from the final word.

The findings provide evidence that the MYC family of oncogenes is a driver of resistance.

Study of patients treated with Tecentriq (atezolizumab) shows the risk of hyperprogression is .7% when the PD-L1 is used as a first-line therapy and 8.8% when it was used in later lines of therapy.

Researchers find an association between depression and biomarkers for inflammation, which may mean a poor prognosis.

South Korean researchers report results that show pencil-beam scanning proton therapy may lower the risk of severe radiation-induced lymphopenia in people treated for lung cancer.


Published: May 22nd 2023 | Updated:

Published: July 31st 2023 | Updated:

Published: June 14th 2023 | Updated: